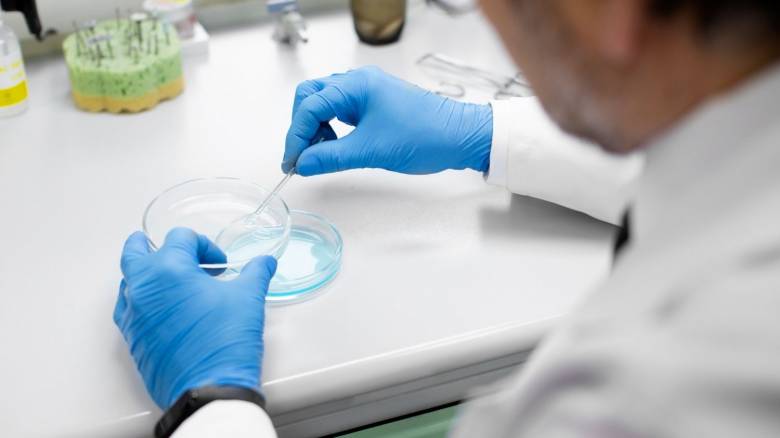
Κυτταρικές θεραπείες: Τι καινούριο φέρνουν σε σοβαρά νοσήματα - Εξηγεί ο καθηγητής Π. Τσιριγώτης

Κυτταρικές θεραπείες: Τι καινούριο φέρνουν σε σοβαρά νοσήματα - Εξηγεί ο καθηγητής Π. Τσιριγώτης
Μέσω των κυτταρικών θεραπειών επιτυγχάνεται ίαση της νόσου σε σημαντικό ποσοστό στους ασθενείς, στους οποίους είχαν αστοχήσει οι συμβατικές θεραπείες
Εξαιρετικά θετικά αποτελέσματα βλέπουν οι ασθενείς που χρησιμοποιούν κυτταρικές θεραπείες, δηλαδή θεραπείες βασισμένες σε ανθρώπινα κύτταρα. Μέσω των κυτταρικών θεραπειών επιτυγχάνεται ίαση της νόσου σε σημαντικό ποσοστό στους ασθενείς, στους οποίους είχαν αστοχήσει οι συμβατικές θεραπείες. Και όταν μιλάμε για ασθενείς με αιματολογικές κακοήθειες, η στοχευμένη θεραπεία και η ιατρική ακριβείας έχουν ιδιαίτερη βαρύτητα και αξία.
Τα παραπάνω ελπιδοφόρα νέα μοιράζεται μαζί μας ο καθηγητής Αιματολογίας ΕΚΠΑ, στο ΑΤΤΙΚΟΝ νοσοκομείο Παναγιώτης Τσιριγώτης, MD. Το κλινικό του έργο εστιάζει στην Οξεία Λευχαιμία με ιδιαίτερη έμφαση στις Κυτταρικές Θεραπείες και την Μεταμόσχευση Αιμοποιητικών Κυττάρων.
Οι κυτταρικές θεραπείες αφορούν κατά κανόνα ασθενείς με αιματολογικές κακοήθειες. Αξίζει να σημειώσουμε ότι η ταυτόχρονη χορήγηση κυτταρικής θεραπείας με κλασική χημειοθεραπεία αντενδείκνυται, όπως τονίζει στην ενδιαφέρουσα συνέντευξη που παραθέτει ο καθηγητής στο CNN Greece, διότι η χημειοθεραπεία μπορεί να καταστρέψει τα γενετικά τροποποιημένα κύτταρα. Μπορεί όμως να χρησιμοποιηθεί πριν από την χορήγηση της κυτταρικής θεραπείας προκειμένου να μειωθεί το καρκινικό φορτίο.
Ωστόσο, είναι ήδη υπό ανάπτυξη κλινικές μελέτες που διερευνούν την ασφάλεια και αποτελεσματικότητα του συνδυασμού της με άλλες ανοσοθεραπευτικές μεθόδους, με πρώιμα ενθαρρυντικά αποτελέσματα.Οι κυτταρικές θεραπείες, επίσης, αφορούν και παιδιά με τα αντίστοιχα νοσήματα των ενηλίκων.

O καθηγητής Αιματολογίας ΕΚΠΑ, στο ΑΤΤΙΚΟΝ νοσοκομείο Παναγιώτης Τσιριγώτης, MD
Ακολουθεί αναλυτικά η συνέντευξη του καθηγητή Παναγιώτη Τσιριγώτη στο CNN Greece:
Θα ήθελα να σας ρωτήσω τι σημαίνει η θεραπεία με την χρήση κυττάρων όταν μιλάμε για τον καρκίνο, αλλά και για κάποια σπάνια νοσήματα, καθώς, όπως το λέει η ίδια η λέξη, μία κυτταρική θεραπεία βασίζεται στα κύτταρα και όχι στα κλασσικά φάρμακα;
Με τον όρο κυτταρική θεραπεία αναφερόμαστε σε μία μεγάλη ομάδα θεραπευτικών μεθόδων που βασίζονται στην χρήση όχι των κλασικών φαρμακευτικών ουσιών αλλά ανθρώπινων κυττάρων. Ο όρος είναι πολύ γενικός και περιλαμβάνει πολλές και διαφορετικές θεραπείες. Η αλλογενής μεταμόσχευση μυελού των οστών είναι π.χ. κυτταρική θεραπεία. Τα τελευταία χρόνια έχει εισαχθεί στην καθημερινή κλινική πρακτική η θεραπεία με CAR-T-cells (ChimericAntigenReceptor T-cells).
Η συγκεκριμένη θεραπεία χρησιμοποιεί τα λεμφοκύτταρα του ίδιου ασθενούς για την καταστροφή των κακοήθων κυττάρων. Τα κύτταρα του ασθενούς συλλέγονται με την χρήση ειδικού μηχανήματος και ακολούθως σε ειδικό εργαστήριο υψηλής τεχνολογίας, τα λεμφοκύτταρα υφίστανται γενετική τροποποίηση που τους δίνει την δυνατότητα να αναγνωρίζουν και να καταστρέφουν επιλεκτικά τα καρκινικά κύτταρα. Τα γενετικά τροποποιημένα λεμφοκύτταρα χορηγούνται στον ασθενή και δια του αίματος κυκλοφορούν στο ανθρώπινο οργανισμό αναζητώντας τα καρκινικά κύτταρα τα οποία και καταστρέφουν με αποτέλεσμα την ίαση. Τα CAR-T cells αποτελούν σήμερα την νεότερη, και πλέον εξελιγμένη μορφή κυτταρικής θεραπείας.
Μπορεί μία κυτταρική θεραπεία να συνδυαστεί με χημειοθεραπεία ή ανοσοθεραπεία σε έναν ογκολογικό ασθενή;
Η κυτταρική θεραπεία, όπως αναφέρθηκε, αποτελεί μία μέθοδο ανοσοθεραπείας, επειδή χρησιμοποιεί το ανοσολογικό σύστημα του ανθρώπινου οργανισμού για την επιλεκτική καταστροφή των καρκινικών κυττάρων και αυτό την διαχωρίζει από την κλασική χημειοθεραπεία, η οποία καταστρέφει ανθρώπινα κύτταρα χωρίς να μπορεί να κάνει διάκριση μεταξύ φυσιολογικών και καρκινικών κυττάρων.
Η ταυτόχρονη χορήγηση κυτταρικής θεραπείας με κλασική χημειοθεραπεία αντενδείκνυται, διότι η χημειοθεραπεία μπορεί να καταστρέψει τα γενετικά τροποποιημένα κύτταρα. Μπορεί όμως να χρησιμοποιηθεί πριν από τη χορήγηση της κυτταρικής θεραπείας με σκοπό την μείωση του καρκινικού φορτίου.
Επί του παρόντος η κυτταρική θεραπεία δεν χρησιμοποιείται συνδυαστικά με άλλες θεραπείες, όμως είναι ήδη υπό ανάπτυξη κλινικές μελέτες που διερευνούν την ασφάλεια και αποτελεσματικότητα του συνδυασμού της με άλλες ανοσοθεραπευτικές μεθόδους, με πρώιμα ενθαρρυντικά αποτελέσματα.
Μία κυτταρική θεραπεία είναι το ίδιο αποτελεσματική για όλους τους ασθενείς; Μπορούν και μικρά παιδιά να λάβουν αυτές τις θεραπείες, καθώς σε πολλές περιπτώσεις, όπως διαβάζουμε, οι κυτταρικές θεραπείες είναι επουλωτικές και αναγεννητικές;
Καμία θεραπεία δεν είναι το ίδιο αποτελεσματική σε όλους τους ασθενείς. Αυτό οφείλεται στο γεγονός ότι τα κακοήθη νοσήματα παρουσιάζουν πολύ μεγάλη βιολογική ετερογένεια που καθιστούν τον κάθε ασθενή μοναδικό. Η λεγόμενη «ιατρική ακριβείας» στοχεύει ακριβώς σε αυτό το σημείο. Με σύγχρονες και πολύ εξελιγμένες τεχνικές προσπαθεί να διακρίνει την ιδιαιτερότητα της νόσου κάθε ασθενούς με σκοπό τη χορήγηση εξατομικευμένης θεραπείας για την βελτιστοποίηση της αποτελεσματικότητας. Η έρευνα αυτή αφορά και τις κυτταρικές θεραπείες.
Στον παρόντα χρόνο οι κυτταρικές θεραπείες είναι αποτελεσματικές σε σημαντικό ποσοστό ασθενών, αλλά δεν δυνάμεθα να προβλέψουμε την ανταπόκριση στην θεραπεία στον κάθε ασθενή εκ των προτέρων.
Οι κυτταρικές θεραπείες αφορούν και παιδιά με τα αντίστοιχα νοσήματα των ενηλίκων. Δεν θα χρησιμοποιούσα τον όρο «επουλωτικές και αναγεννητικές» για τις υφιστάμενες κυτταρικές θεραπείες οι οποίες στοχεύουν στην θεραπεία κακοήθων νόσων. Κυτταρικές θεραπείες για αναγέννηση ιστών και οργάνων είναι σε πολύ πρώιμα ερευνητικά στάδια και στο απώτερο μέλλον θα δούμε εάν και πώς θα χρησιμοποιηθούν θεραπευτικά.
Ποια τα οφέλη των κυτταρικών θεραπειών σε ασθενείς με αιματολογικά νοσήματα;
Οι κυτταρικές θεραπείες αφορούν κατά κανόνα ασθενείς με αιματολογικές κακοήθειες. Τα CAR-T cells χρησιμοποιούνται στην θεραπεία της οξείας λεμφοβλαστικής λευχαιμίας, του πολλαπλού μυελώματος και αρκετών υπότυπων των Non-Hodgkin λεμφωμάτων. Τα οφέλη από την κλινική εφαρμογή τους είναι εξαιρετικά εάν αναλογιστούμε ότι επιτυγχάνεται ίαση της νόσου σε σημαντικό ποσοστό ασθενών στους οποίους είχαν αστοχήσει οι συμβατικές θεραπείες.
Υπάρχουν δημοσιευμένες μελέτες ή κλινικές μελέτες που «τρέχουν» σήμερα και καταδεικνύουν τη θεραπευτική αποτελεσματικότητα των κυτταρικών θεραπειών σε ογκολογικούς ασθενείς, αλλά και σε ασθενείς με πολύ σοβαρά και σπάνια νοσήματα;
Η εφαρμογή των κυτταρικών θεραπειών δεν έχει βρει μέχρι στιγμής αντίστοιχη θέση στην θεραπεία των ογκολογικών ασθενών. Υπάρχουν, όμως, κλινικές μελέτες σε εξέλιξη που αφορούν ογκολογικούς αλλά και ασθενείς με άλλα μη-κακοήθη νοσήματα όπως αιμοσφαιρινοπάθειες, τα αποτελέσματα των οποίων αναμένονται.
